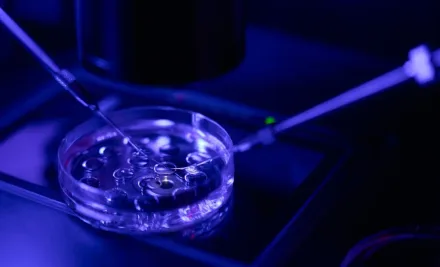
Intrazytoplasmatische Spermieninjektion (ICSI) – Ablauf, Anwendung und Erfolg

This site is protected by reCAPTCHA and the Google. Privacy Policy and Terms of Service apply.
Wir stehen Ihnen bei Ihrer IVF-Behandlung stets zur Seite! Wir rufen Sie an.
- info@zypernivf.com
- Şht. Erdoğan Mustafa Sok. No:19 Yenisehir, Lefkoşa / TRNC
Unser erfahrener Koordinator wird Sie in Kürze kontaktieren.